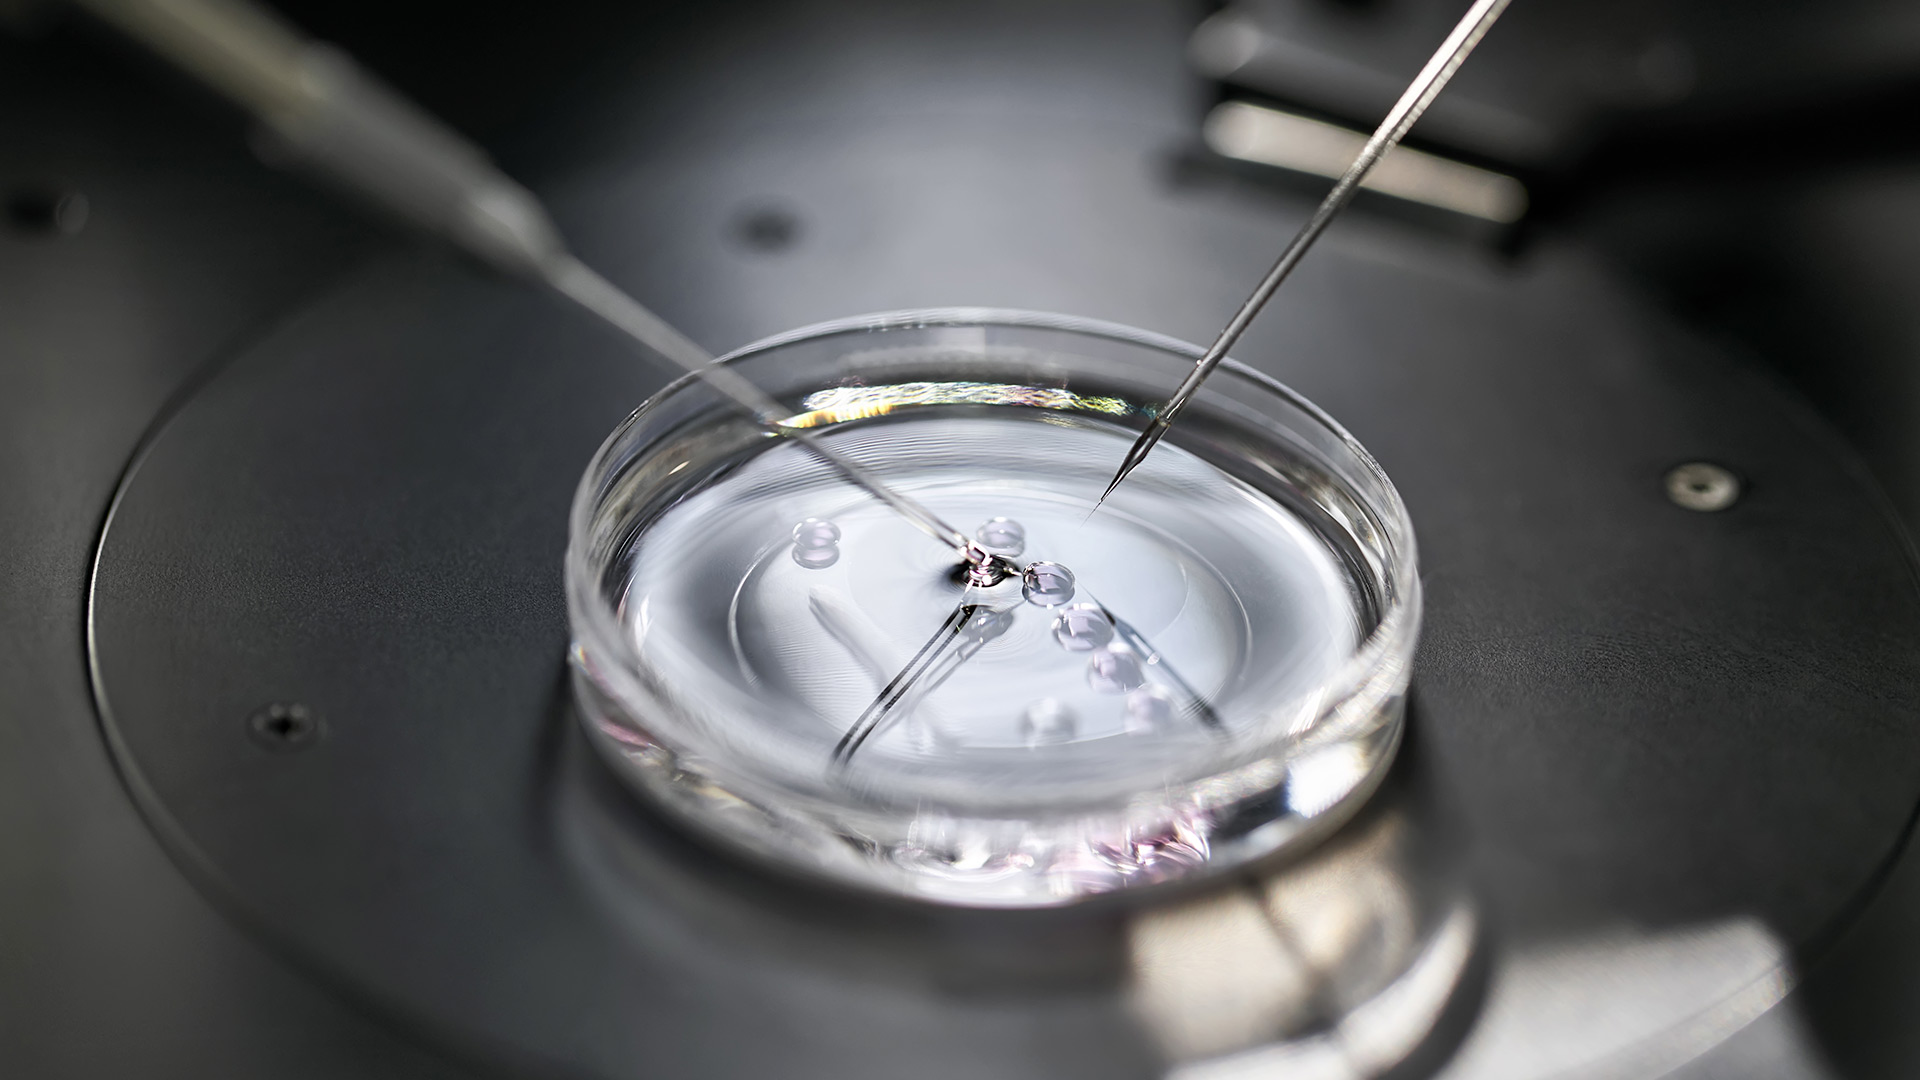

Publication
The litigation brief
In today’s fast-evolving legal landscape, litigation is becoming more complex, more international, and more strategic than ever before. Understanding the challenges, trends and lessons learned is critical for businesses and their litigation strategy and risk management.